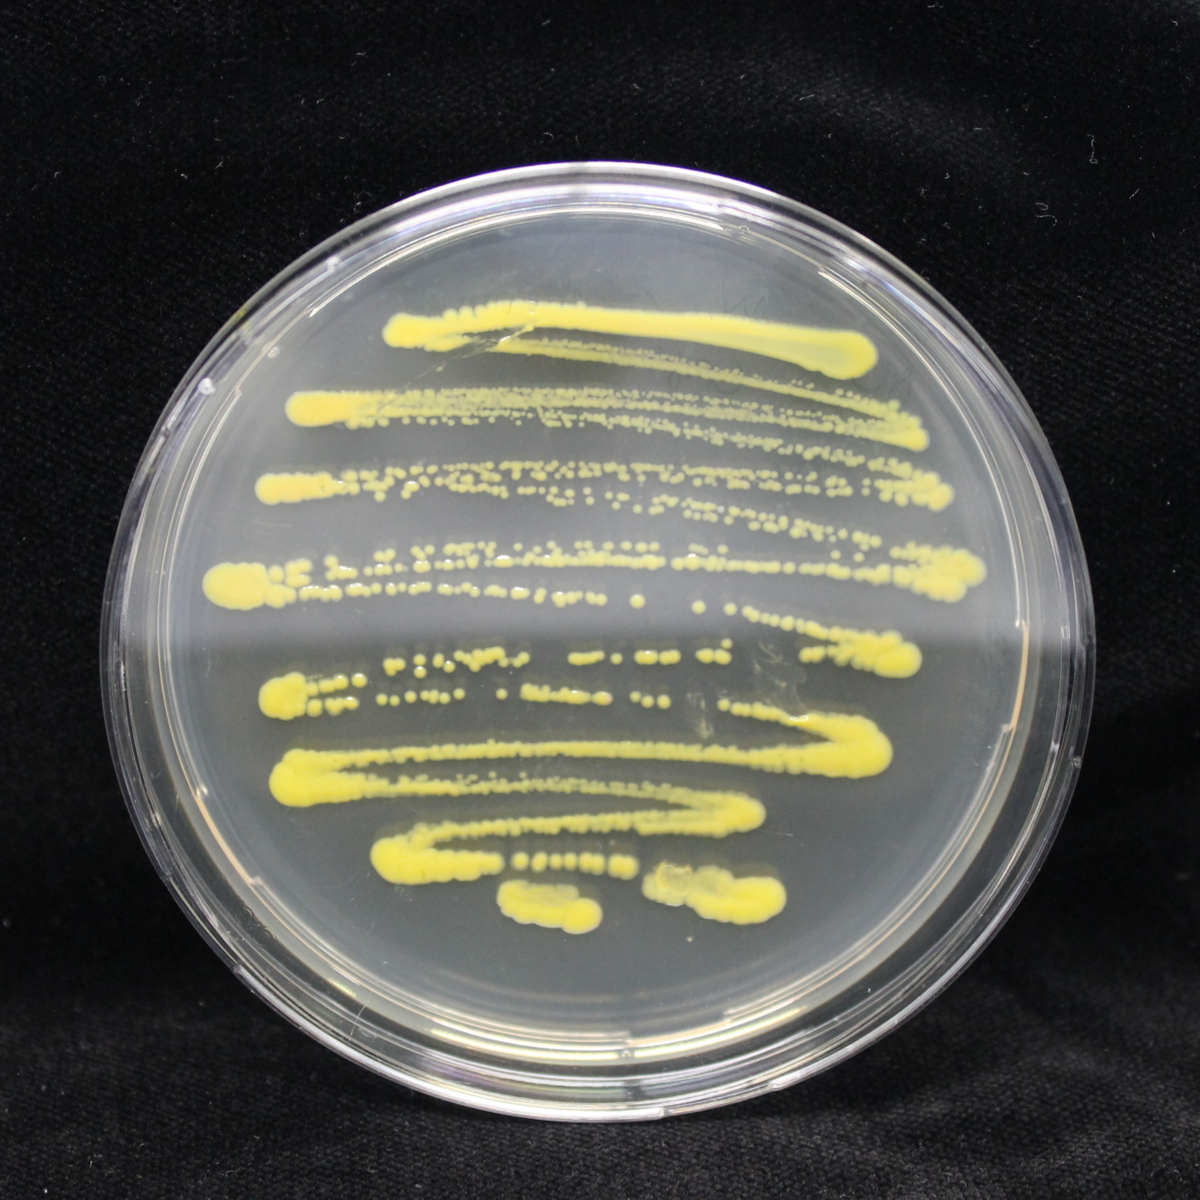

By turning biotechnology into a business, Vienna Textile Lab proves that sustainability, research and intellectual property (IP) go hand in hand. Founder Karin Fleck’s patented microbial dyes show how protecting innovation can attract investors, build credibility, and turn scientific ideas into global opportunities for a cleaner and circular textile industry.
By Intellectual Property Institute Luxembourg (IPIL)When Karin Fleck left her career in the oil and energy sector to establish her business, Vienna Textile Lab (VTL GmbH), she knew she was stepping into a delicate territory. With a background in chemistry from TU Vienna and RMIT Melbourne, she had spent years managing large-scale industrial projects before deciding to tackle a problem that had long been hidden in plain sight: the environmental cost of chemical textile dyes.
Synthetic dyes, largely derived from petrochemicals, are among the world’s most polluting materials. Karin envisioned an alternative; one that relied not on fossil fuels, but on living systems. This became the foundation of Vienna Textile Lab, a start-up dedicated to researching and commercialising microbial pigments made by bacteria and fungi. The goal was clear: replace toxic synthetic dyes with bio-based ones that are traceable, safe, and sustainable.
While walking along this innovative domain, her transformation from energy executive to biotech entrepreneur, also meant learning to navigate an entirely new world of IP. She soon understood that in an emerging field, where science and creativity intersect, protecting innovations would be as critical as making them.
Route to the patented innovation
With more fashion brands seeking cleaner, traceable materials, VTL has found itself in the spotlight of a rapidly growing field with high competition. To stay ahead and attract clients and investors, Karin and her team decided to build a robust IP framework early on.

“The area of microbial pigments in IP has seen an enormous uptake in the past years,” says Karin. “That motivated us while putting a lot of pressure on us to understand where to focus our efforts,” she continues.
In the early years of Vienna Textile Lab, IP was a constant challenge and one of their core conversation topics in the team.
Karin still remembers a couple of lost business opportunities because of unprotected assets.
“These days are now behind us, after integrating IP management principles into our business strategy, we are now moving more freely and bravely thanks to our not so large but efficient patent portfolio”, Karin proudly adds.
Today, Vienna Textile Lab holds two patents; one for microbial dyeing and another for printing, covering key processes in applying bio-based pigments, which helped position the company as a serious player in sustainable technology and opened new doors for collaboration. The existence of this portfolio also gave investors the confidence that VTL was not just a research initiative, but a scalable business.
The hurdles and the lessons
Like most pioneering start-ups, Vienna Textile Lab’s IP journey came with its share of hurdles. The first one was evaluating and demonstrating what was truly novel and inventive. In a lab with full of experiments, distinguishing an invention from a scientific finding and presenting it in a patent document required both technical insight and legal literacy.
Drafting claims that captured the essence of their innovation was time-consuming and often intimidating, but the IP professionals they worked with didn’t let them walk alone. Karin confirms, “Without our IP lawyers, we could not manage the process and the implementation. Finding the right team was a crucial step”.
The process of technology transfer added another layer of complexity. Negotiating fair agreements with partners, some of whom were unfamiliar to IP, demanded both diplomacy and foresight. The financial aspect of applying for a patent was also another challenge, which forced them to take strategic decisions and seek for external funding mechanisms.
Even after patents were filed, there were some other issues to consider such as exploitation and enforcement routes in different jurisdictions. All these experiences taught Karin and her team to focus on protection as part of their core assets, while planning for future licensing opportunities in key markets such as Asia.
Building an IP strategy suited to the company’s needs
Vienna Textile Lab’s approach to IP matured all along the way. The company’s first registered right was not a patent but a trademark, a symbolic and accessible entry point into the world of IP, or a “soft start” as Karin describes.

From there, a culture of internal IP awareness has been developed: employees are encouraged to identify new ideas, draft invention disclosures, and contribute to the innovation roadmap.
Karin believes that a good IP strategy starts with people. “Building a solid IP strategy means creating opportunities for everyone in the company to participate by learning, brainstorming, and writing invention disclosures. With every patent filing, you learn something new.”
She also underlines that an effective IP strategy must be tailor-made to the company and does not always mean patenting. For example, in her start-up, they also learned when not to patent. This balanced approach enables both openness for collaboration and control over key know-how.

Getting prepared to tomorrow’s challenges through IP support and partnerships
Vienna Textile Lab’s IP success is also a story of leveraging public support. For VTL, national and European initiatives have been key allies. Austrian and European initiatives played a decisive role in guiding and funding its protection strategy. Early grants from the Austrian Promotional Bank (AWS), including PreSeed, Seedfinancing, and Green. IP programmes, provided both financial and educational support.
The Austrian Research Promotion Agency’s (FFG) Patentscheck programme offered expert assessment from the Austrian Patent Office, while tailored training sessions helped Karin’s team understand how to structure and draft patents. Through the EU projects WORTH and ELIIT, the company gained experience in managing IP across collaborations between creatives and technologists all around Europe.

Karin acknowledges that this ecosystem of support has been fundamental: “These programmes gave us not only resources but knowledge and confidence which are the building blocks of an effective IP culture”.
Today, Vienna Textile Lab is entering the next phase of its journey: turning IP into partnerships and revenue. The company plans to scale its reach through licensing agreements, particularly in Asia, where much of the global textile production takes place.
Karin sees this as the natural evolution of a well-protected innovation: “For an entrepreneur, the focus should be on commercialisation and licensing. IP gives you the structure and credibility to do that safely”.
Lessons in colour and courage
Karin’s advice to other entrepreneurs is simple yet powerful: “Always build your IP, at any stage of your company”. She acknowledges the challenges such as the costs, the paperwork, the waiting, but insists that the payoff is worth it.

Vienna Textile Lab’s story illustrates how scientific invention, creative courage, and IP awareness can combine to reshape an industry. What began as one woman’s response to environmental harm in fashion has become a company that gives colour a new meaning: one defined by biology, sustainability, and strategy.
The message is clear: success in deeptech and design is not only about innovation itself but about protecting and leveraging it effectively.
Images - Courtesy of Vienna Textile Lab
This Case Study was created under Creative FLIP, an EU co-funded project aimed at further increasing the long-term resilience of the CCSI in key areas such as Finance, Finance, Learning, Working Conditions, Innovation & Intellectual Property Rights.
Key Takeaways
• Building Intellectual Property (IP) and integrating it into your business model early creates credibility and unlocks investment opportunities.
• Patents are not just legal assets but also commercial tools that attract investors and partners.
• National and EU support programmes can accelerate IP literacy and protection, and help you find your way in your business.
• Internal IP awareness and culture are crucial for long-term innovation success.

Karin Fleck is the founder and CEO of Vienna Textile Lab (VTL), an innovative start-up in Austria specialised in developing bio-based textile dyes and pigments. Holding a PhD in Applied Chemistry from RMIT University in Melbourne, Karin has over 10 years of international management experience in the field of business planning and strategy.